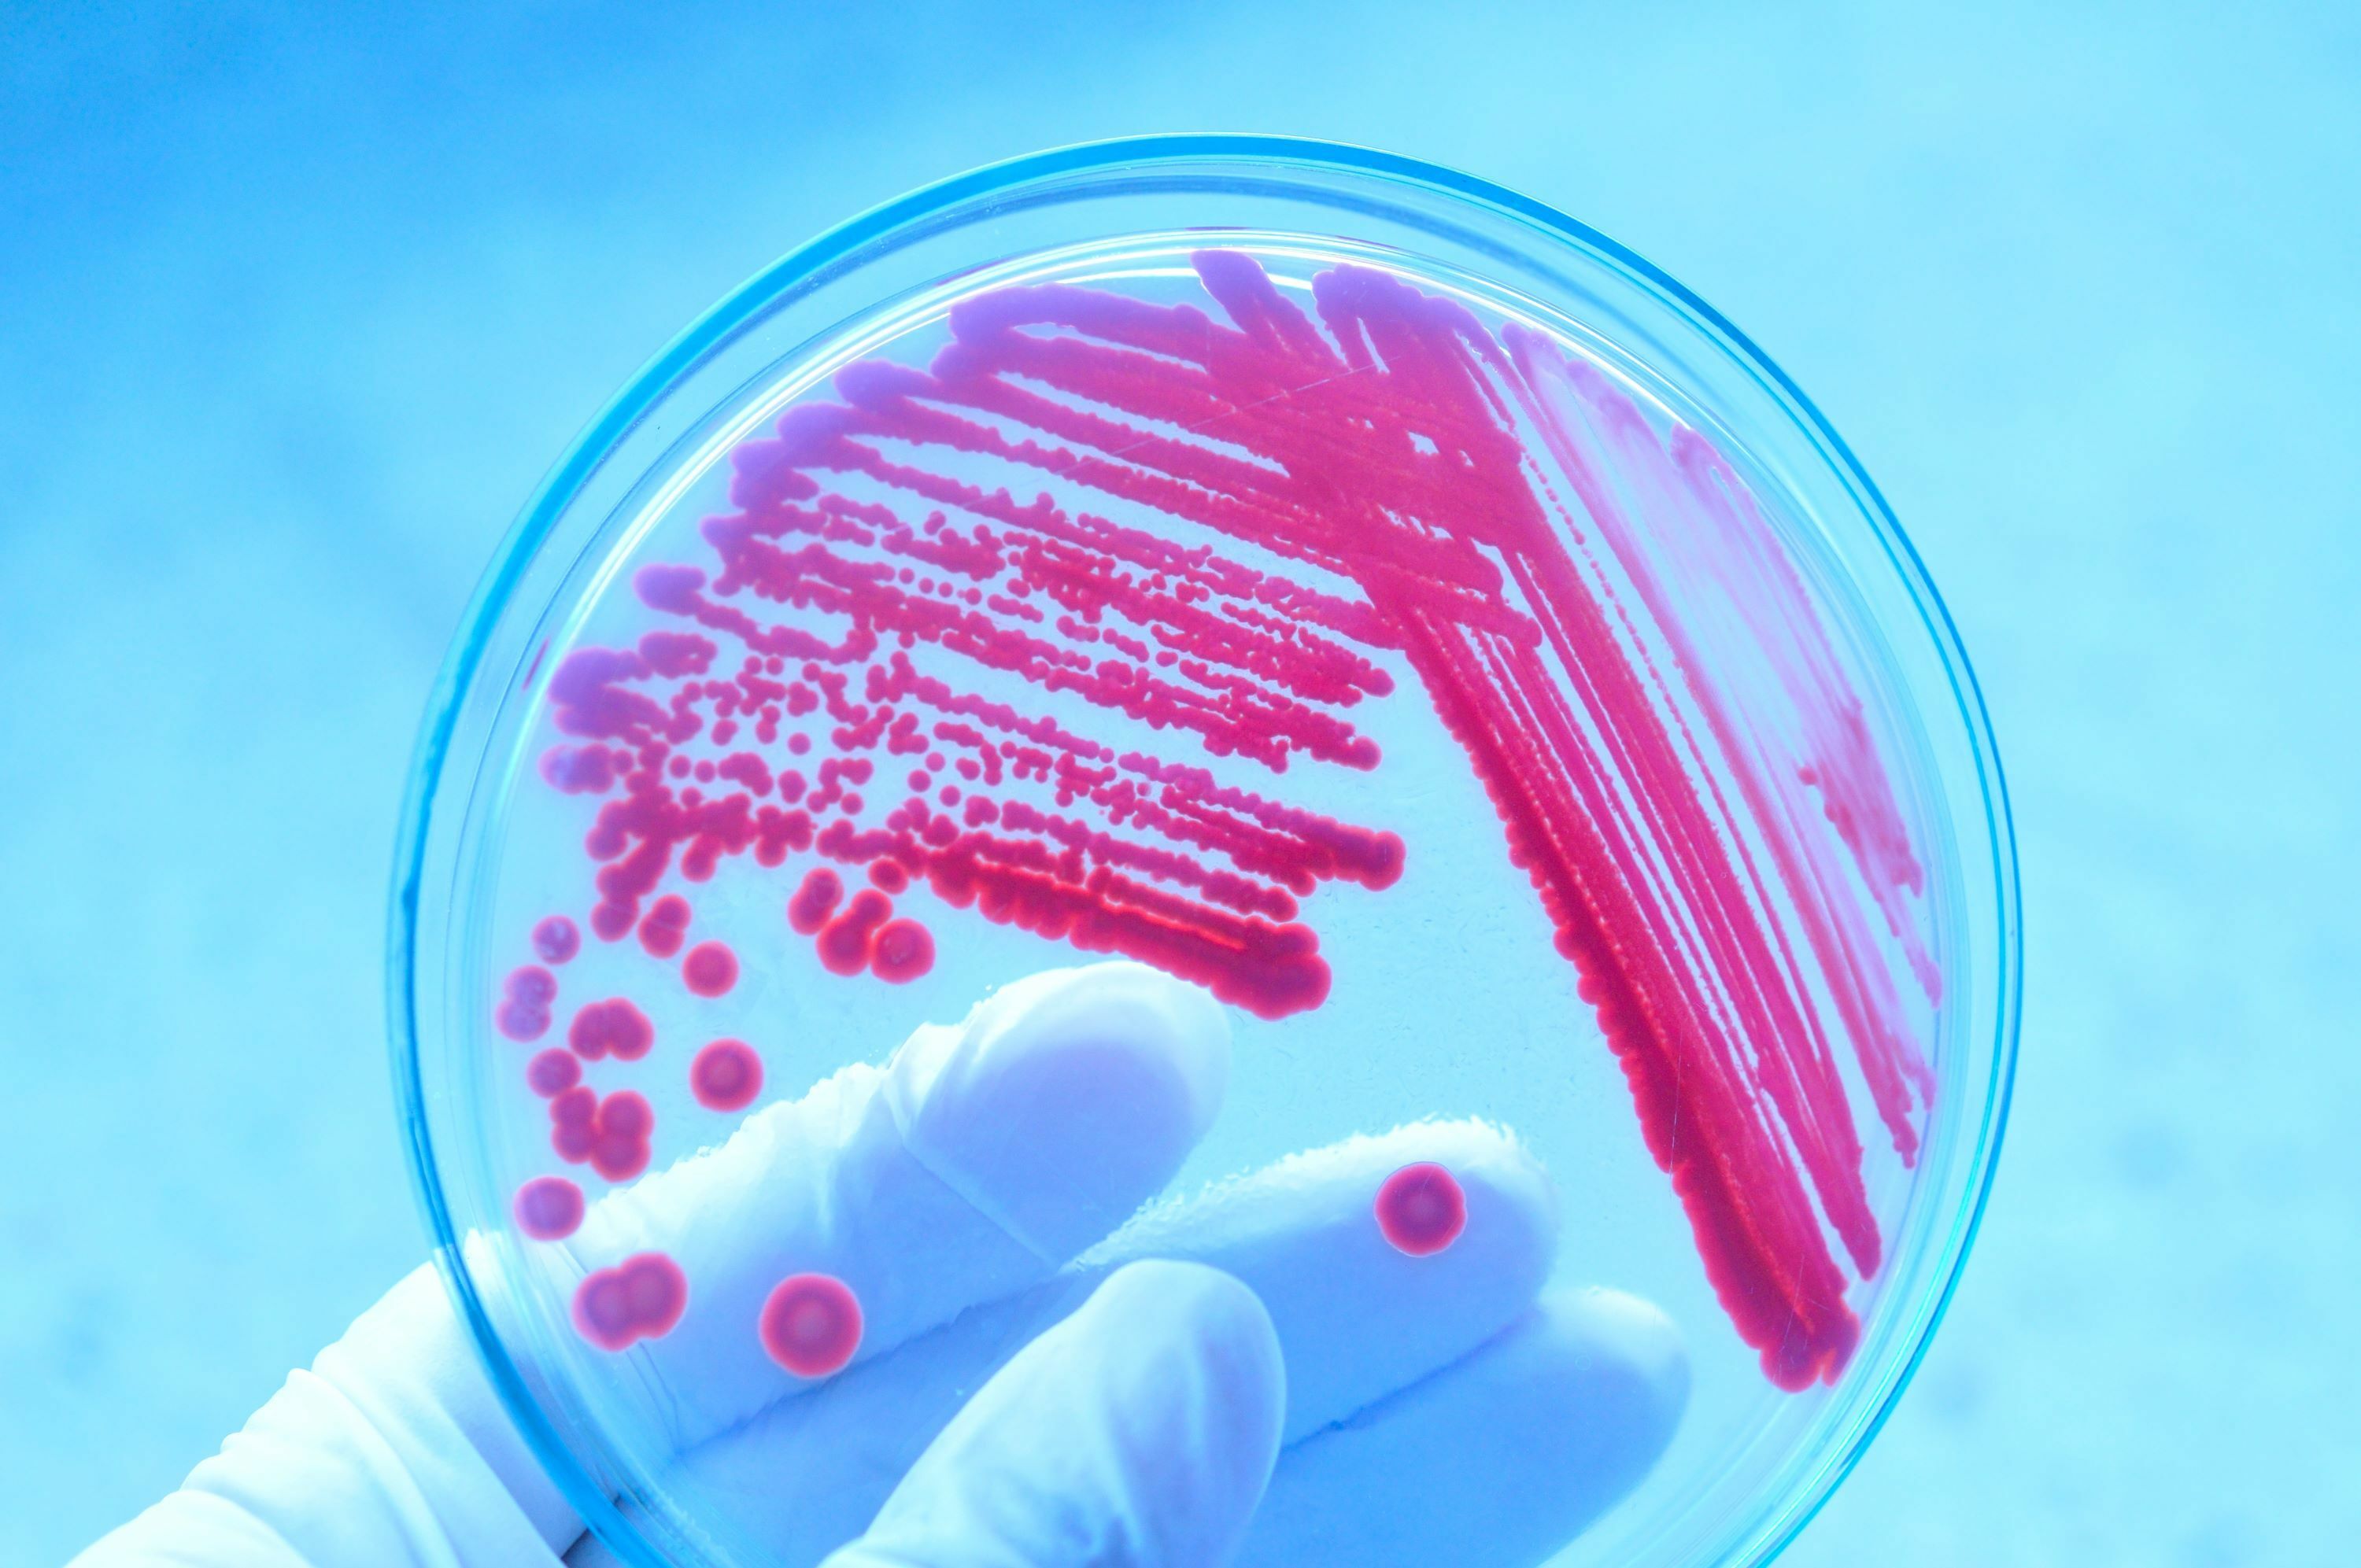
VR Mikrobiolog

Adjunkt
En adjunkt er en lærer med en fireårig lærerutdanning eller som har en bachelorgrad og praktisk pedagogisk utdanning. Som lærer arbeider adjunkter med barn, unge og voksne i skolen.

Tenker du på en utdanning innen realfag og teknologi? Her finner du en oversikt over ulike yrker innen disse fagene. Det finnes sikkert enda flere, mulighetene er mange.

En adjunkt er en lærer med en fireårig lærerutdanning eller som har en bachelorgrad og praktisk pedagogisk utdanning. Som lærer arbeider adjunkter med barn, unge og voksne i skolen.

Allmennlegen er som regel den som møter pasienten først, og mange jobber som fastlege.

Anestesilegen har ansvar for å gi pasienter bedøvelse og smertelindring.

Som arbeidsmedisiner er du lege med spesialisering på sykdommer som oppstår i arbeidsmiljøet.

En arealplanlegger jobber med planlegging og utvikling av områder, ofte en kommune, en by eller en region.

Arkitekter jobber med å utforme hus, bygninger og byer og steder.

En astronaut er utdannet til å enten manøvrere eller arbeide ombord i et romfartøy.

Astronomer studerer objekter og fenomener i universet, som planeter, galakser og stjerner.

En barne- og ungdomspsykiater er lege med videreutdanning i behandling av barn og ungdom med psykiske lidelser.

Som barnehagelærer er du med på å skape et trygt og omsorgsfullt miljø for barn gjennom lek, læring, omsorg og dannelse.

En barnekirurg er en lege som har spesialisert seg på operasjoner hos barn.

Som barnelege er du lege med spesialisering på barnesykdommer.

Som bioingeniør samler du inn og analyserer blodprøver og andre typer biologisk prøvemateriale.

En biokjemiker forsker på biokjemiske prosesser i levende organismer.

Biologer jobber med dyre- og planteliv og arbeider både ute i felt og på laboratorier.

Bioteknologer bruker avansert teknologi til å utvikle nye biologiske produkter.


Branningeniører jobber med bygnings- og brannsikkerhet. Blant de viktigste arbeidsoppgavene er å gjennomføre kontroller og gi råd.

Som bryst- og endokrinkirurg behandler du sykdommer i bryst, skjoldbruskkjertel og biskjoldbruskkjertel.

Byggingeniøren utreder, planlegger og gjennomfører byggeprosjekter. Ofte er byggingeniøren lederen på en byggeplass.


Som dataingeniør jobber du med systemutvikling og drift av maskiner eller systemer.

Elektroingeniører arbeider med forbedring av eksisterende teknologi og utvikling av nye teknologiske løsninger.


En faglærer og yrkesfaglærer er en lærer med spesiell kompetanse innenfor et fagfelt.

En farmasøyt er en ekspert på legemidler.



Fysikere jobber med alt fra studiet av små partikler til hvordan universet fungerer.

En førsteamanuensis har meget høy kompetanse innen sitt fagfelt, og jobber med undervisning og forskning i høyere utdanning.

Geofysikere skal forklare, og noen ganger forutse, det som skjer i jordas indre og ytre.

En geokjemiker undersøker kjemiske prosesser i jordas indre og overflate, havet og atmosfæren.

Geologi er læren om jordens sammensetning, oppbygging og utvikling fra opprinnelsen og fram til i dag.

Som geriater er du spesialist på sykdommer hos eldre mennesker.

En gründer er en person som har startet og driver egen virksomhet.

En grunnskolelærer arbeider med elever fra 1–10. klasse.

En gynekolog er en lege med spesialisering i faget kvinnesykdommer og fødselshjelp.

Som havforsker kan du forske på alt fra bittesmå plankton til store sjøpattedyr. Du kan undersøke havbunnens geologi eller du kan studere havets kjemi eller fysikk – som havstrømmer, bølger og tidevann.

En hematolog er en lege som har spesialisert seg på å behandle blodsykdommer.

Som HMS-ingeniør skal du bidra til å bedre helse, miljø og sikkerhet på arbeidsplassen.

En hudlege er en lege med spesialisering innen hudsykdommer og seksuelt overførte sykdommer.

Som hydrolog jobber du med problemstillinger knyttet til utnyttelse av vannressurser.

Som indremedisiner er du lege med spesialisering på sykdommer i indre organer.

Industridesignere utformer produkter, tjenester, programvarer og systemer for privat næringsliv og offentlig sektor.

Ingeniører utvikler nye teknologiske løsninger og sikrer teknologiske systemer vi har i dag.

Ingeniører i energi- og miljø i bygg jobber med å lage gode løsninger innen energi og miljø i nye og gamle bygninger.

En kardiolog er en lege med spesialisering i hjertesykdommer.

En kirurg er en lege som opererer pasienter, i tillegg til annen behandling.

En kjemiingeniør arbeider med kjemiske prosesser.

En kjemiker undersøker hvordan verden rundt oss er konstruert helt ned til de minste bestanddeler.

En kjeveortoped er en tannlege som har spesialisert seg på å behandle feil i tannstilling og bitt.

Laboranten jobber med analyse, produktutvikling og rapportering.

En landmåler måler opp og markerer grenser i terrenget.

Som lege stiller du diagnose og behandler sykdommer og skader hos mennesker.

En lektor er en lærer med mastergrad fra universitet eller høgskole.


Som spesialist i lungesykdommer behandler og overvåker du sykdommer i luftveisorganene.

En lærer underviser både barn og voksne i ulike fag.


Marine bioteknologer jobber ofte som produktutviklere.

Marinbiologer forsker på vekster, dyr og organismer i vann.

En matematiker arbeider med ulike anvendelser av matematikk, matematisk forskning eller undervisning.

En matteknolog jobber med produktutvikling og kontroll av matvarer.

Meteorologen jobber med å forstå og formidle vær.
Mikrobiologer studerer én- og fåcellede organismer slik som bakterier, sopp, virus og amøber.


Naturforvalteren tar vare på miljøet og naturressursene rundt oss.

Som nevrokirurg er du lege med spesialisering i å operere i hjerne, nervesystem og ryggmarg.

Som nevrolog er du lege med spesialisering på sykdommer i nervesystemet.

En nukleærmedisiner er en lege som benytter radioaktive stoffer til undersøkelse og behandling av pasienter.

En nyrelege er en lege og indremedisiner som har spesialisert seg på sykdommer i nyrene.



Som onkolog er du en lege som behandler pasienter med kreft.

En ortoped er en lege som forebygger og behandler sykdommer og skader i muskler og skjelett.

Som oseanograf jobber du med å forstå fenomener i havet, som hvordan havet påvirkes av jorden, og jorden påvirkes av havet.

En patolog er en lege som undersøker forandringer i organer, vev og celler.

En pedagog er en person som har studert pedagogikk, enten i lærerutdanningen, barnevernsutdanningen eller som eget fag på universitetet.

Som petroleumsingeniør arbeider du innenfor olje- og gassbransjen, gjerne med ansvar for områder som produksjon, boring eller reservoar.

En planteinspektør jobber med kontroll av planter, ofte i forbindelse med import og eksport.

Som plastikkirurg hjelper du pasienter med å få tilbake normalt utseende og funksjon etter operasjoner, skader eller misdannelser. Du kan også utføre kosmetisk kirurgi for å endre folks utseende av estetiske grunner.

Som prosessingeniør utvikler og drifter du prosessanlegg.


Provisorfarmasøyter er eksperter på legemidler, både hvordan de lages, brukes og virker i kroppen.

Psykiateren er en lege som utreder og behandler personer med psykiske lidelser.

En radiolog er en lege som har spesialisert seg på arbeid med røntgen, CT, MR og ultralyd.

Reseptarfarmasøyter veileder i riktig bruk av legemidler, ekspederer resepter og gir råd til kunder i apotek.

Som revmatolog behandler du betennelse og andre lidelser i kroppens organer, ofte i ledd og ryggsøyle.

Som romteknolog jobber du med alle typer romrelatert teknologi.

Som samfunnsmedisiner jobber du for å fremme og forbedre helsen hos befolkningen.

Sivilingeniører utvikler teknologiske løsninger, og jobber med forskning, utvikling, undervisning, prosjektarbeid og ledelse.

En skadedyrbekjemper hjelper bedrifter og privatpersoner med å bli kvitt skadedyr.

Som spesialist i fordøyelsessykdommer er du lege og indremedisiner med spesialisering på sykdommer i fordøyelsessystemet.

En spesialpedagog legger til rette for gode lærings- og oppvekstvilkår for personer som har særskilte læringsbehov.

En spillprogrammerer jobber med å lage spillopplevelser.

Som tannlege behandler du sykdommer i munnhule og kjeve.

En thoraxkirurg er en lege som har spesialisert seg på å utføre operasjoner i brystkassen.

Urolog er en lege og kirurg med spesialisering i sykdommer i nyrene, urinveier og kjønnsorganer.

Veterinæren behandler og forebygger sykdommer hos dyr, men jobber også med mattrygghet og dyrevelferd.



Som øre-nese-hals-spesialist er du lege med spesialisering på sykdommer i øre, nese og hals.

Øyeleger stiller diagnose og behandler sykdommer i øyet.